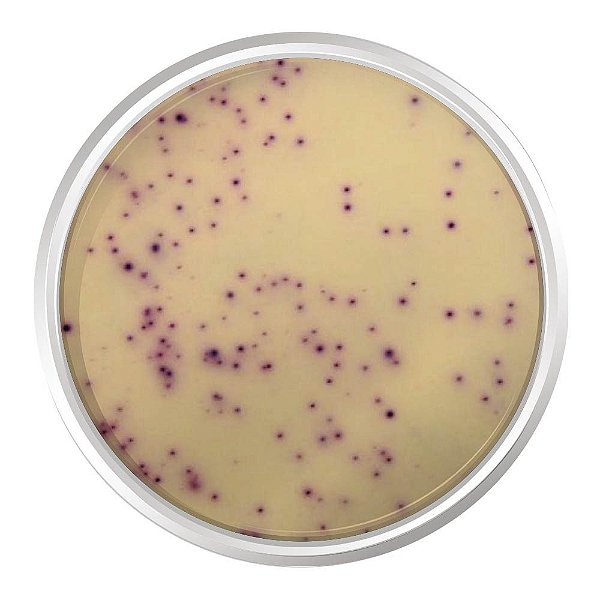
AGAR CROMOGENICO CONTAGEM DE PLACAS (PCA) 500G - KASVI

AGAR CROMOGENICO CONTAGEM DE PLACAS (PCA) 500G - KASVI
AGAR CROMOGÊNICO CONTAGEM DE PLACAS (PCA). FRASCO 500 G
Aplicação:
O Agar Cromogênico Contagem de Placas (PCA) é um meio utilizado para contagem total de placas em amostras de alimentos.
Preparo:
Suspender 23,6 gramas do meio em 1 litro de água destilada. Mexer bem e dissolver o meio com frequente agitação e aquecimento. Ferver por 1 minuto até a completa dissolução. EVITAR O SUPERAQUECIMENTO. NÃO AUTOCLAVAR. Dispensar em placas de Petri. O meio preparado deve ser armazenado entre 8°C a 15°C.
Especificações Técnicas:
Composição g/L
Enzimático Digestivo de Caseína 5,00
Extrato de Levedura 2,50
Glicose 1,00
Mistura Cromogênica 0,12
Agar Bacteriológico 15,0
pH Final de 7,0 ± 0,2 a 25°C.
Aparência do Meio:
DESIDRATADO: Pó de cor bege, fluído e homogêneo.
PREPARADO: Âmbar levemente opalescente.
Controle de Qualidade:
Microrganismos Crescimento Cor da Colônia
Escherichia coli ATCC 8739 Bom Magenta
Salmonella thyphimurium ATCC 14028 Bom Magenta
Staphylococcus aureus ATCC 25923 Bom Magenta
Enterobacter aerogenes ATCC 13048 Bom Magenta
Staphylococcus epidermidis ATCC 12228 Bom Magenta
Candida albicans ATCC 10231 Bom White
Armazenamento:
Após aberto manter o frasco bem fechado e de cabeça para baixo evitando a hidratação. Armazenar em local seco, longe da luz e da umidade entre 2°C a 8°C.
Descarte:
O descarte deverá ser realizado de acordo com as normas nacionais e regulamentações locais em vigor.
Registro ANVISA:
Não aplicável.
Apresentação:
Frasco com 500 gramas.
MODELO: K25-1585
MARCA: KASVI
*MEIO VENDIDO SOB DEMANDA.
Sinônimos: Standard Methods Chromogenic Agar (P.C.A).
OBS: Imagem meramente ilustrativa do resultado típico em placa
Produtos relacionados
-
 AGAR CROMOGENICO SALMONELLA 500G - KASVIR$ 3.739,28até 6x de R$ 623,21 sem jurosou R$ 3.664,49 via Pix
AGAR CROMOGENICO SALMONELLA 500G - KASVIR$ 3.739,28até 6x de R$ 623,21 sem jurosou R$ 3.664,49 via Pix -
 AGAR CROMOGENICO CANDIDA PLUS 500G - KASVIR$ 2.733,15até 6x de R$ 455,52 sem jurosou R$ 2.678,49 via Pix
AGAR CROMOGENICO CANDIDA PLUS 500G - KASVIR$ 2.733,15até 6x de R$ 455,52 sem jurosou R$ 2.678,49 via Pix -
 AGAR CROMOGENICO LISTERIA BASE (ISO 11290-1) 500G - KASVIR$ 1.372,70até 6x de R$ 228,78 sem jurosou R$ 1.345,25 via Pix
AGAR CROMOGENICO LISTERIA BASE (ISO 11290-1) 500G - KASVIR$ 1.372,70até 6x de R$ 228,78 sem jurosou R$ 1.345,25 via Pix -
 AGAR CROMOGENICO E.COLI COLIFORMES (CCA) ISO 9308-1 500G - KASVIR$ 5.223,84até 6x de R$ 870,64 sem jurosou R$ 5.119,36 via Pix
AGAR CROMOGENICO E.COLI COLIFORMES (CCA) ISO 9308-1 500G - KASVIR$ 5.223,84até 6x de R$ 870,64 sem jurosou R$ 5.119,36 via Pix
-
A Lab-Bran atua há mais de 20 anos entregando insumos com precisão, responsabilidade e documentação correta pra quem não pode errar no laboratório. Atendemos hospitais, clínicas médicas e veterinárias, universidades, laboratórios de análises, indústrias e agronegócio — com estoque técnico e emissão fiscal pronta pra cada tipo de cliente. Seja qual for sua área, se você precisa de insumos confiáveis, pode contar com a Lab-Bran.